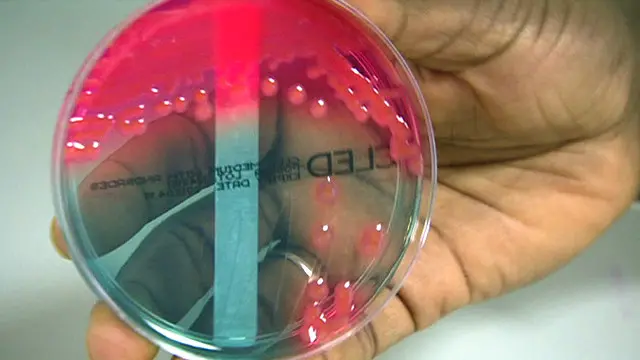

سؤال وجواب: نمو مقاومة الجراثيم للمضادات الحيوية

صدر الصورة، SPL
لماذا يتوقف تأثير المضادات الحيوية؟
تهدف المضادات الحيوية إلى قتل أو منع نمو البكتريا، ولكن ليست جميع البكتريا تتأثر بذلك، فبعض هذه البكتريا تتمتع بمناعة طبيعية، وتزداد مقومتها على نحو تلقائي مع توافر فرصة للتحور، ومن ثم تتكاثر وتنمو سلالات أكثر مرونة، بين عشية وضحاها، وتتكاثر الجرثومة الواحدة لتصبح مليون.
وعندما يعطى المضاد الحيوي المختار يقتل البكتريا الحساسة، لكن تظل أي بكتريا مقاومة على قيد الحياة. كما يمكن انتقال المقاومة من أنواع بكتيرية إلى أخرى.
هل الاستخدام المفرط للمضادات الحيوية مسؤول عن ذلك؟
كلما أفرط المريض في استخدام المضادات الحيوية، زادت فرص وجود بكتريا تطور من طريقة مقاومتها، ويخشى الخبراء من استخدام المضادات الحيوية بطريقة غير منضبطة وما ينجم عن ذلك من تأثير.
فكثيرون يتناولون المضادات الحيوية ويستخدمونها حال الإصابة بعدوى متوسطة لا يلزم مكافحتها بالمضادات الحيوية، كما لا يمكن للمضادات الحيوية أن تساعد في التعافي من العدوى الناجمة عن الفيروسات مثل فيروسات الإنفلونزا على سبيل المثال.
وثمة قضية أخرى تتمثل في أولئك الذين يتقاعسون عن تناول الجرعة الكاملة للمضادات الحيوية خلال الفترة العلاجية المحددة، فإيقاف العلاج مبكرا يعني أن البكتريا المعنية بالعلاج قد تطور مقاومة لذلك المضاد الحيوي.
ويعتقد أن الاستخدام الواسع النطاق للمضادات الحيوية في الحيوانات قد أدى إلى نشوء سلالات بكتيرية لديها مقاومة يمكن أن تنتقل للبشر عن طريق الغذاء.
هل يزداد الأمر سوءا؟
يخشى الخبراء من أن نصل إلى مرحلة تصبح فيها بعض الأنواع السابقة من العدوى غير قابلة للسيطرة عليها عن طريق استخدام المضادات الحيوية.
فبكتريا ستافيلوكوكاس أوريوس المقاومة للمثيسلين (MRSA) لديها مقاومة حاليا للعديد من الأدوية، كما أصبح من الصعب علاجها.
وهناك مؤخرا حالات لمرض السيلان والتي تنتقل عن طريق ممارسات جنسية أصبح لديها مقاومة لجميع أنواع المضادات الحيوية العادية التي تستخدم لمكافحة العدوى.
ونرصد حالات لمرض السل متعددة المقاومة للأدوية وظهور تهديدات نوع جديد من البكتريا المقاومة مثل نوع "نيو دلهي" (NDM-1).
كما توجد حاليا مقاومة لأدوية تستخدم عندما تفشل أدوية أخرى، مثل "كولستين"، وهو ما دفع بعض العلماء إلى التحذير من أننا على أعتاب "حقبة ما بعد المضادات الحيوية".
وتنتشر البكتريا المقاومة عن طريق الاتصال المباشر بشخص أو حيوان لديه نفس العدوى بنفس الطريقة التي تنتشر بها بكتريا أخرى. وتعتبر المقاومة مشكلة خاصة في المستشفيات وأماكن أخرى مثل دور رعاية المسنين حيث يوجد تجمعا كبيرا للنزلاء من ضعاف الصحة.
كما يعني كثرة السفر في أنحاء العالم أن أولئك الذي يحملون بكتريا مقاومة في بلد يمكن نشرها في بلد آخر بسرعة.

لماذا لا يوجد لدينا مضادات حيوية جديدة على نحو كاف؟
تؤكد شركات صناعة الأدوية باستمرار على وجود أبحاث تهدف إلى انتاج مضادات حيوية جديدة وتطوير أمصال جديدة للوقاية من العدوى الشائعة.
لكن هذه المشروعات باهظة التمويل وما تعنيه من فعالية وتكلفة بالنسبة للشركة قد يؤدي إلى تراجع الاهتمام بها مقارنة بأعمال تجارية أخرى.
وتكون مدة العلاج بالمضادات الحيوية عادة قصيرة جدا، أيام أو أسابيع، ومن المستحسن أن يقتصد الأطباء في وصفها للمساعدة في تجنب حدوث مقاومة بكتيرية.
فإن حدثت مقاومة كبيرة، يجب إلغاء العقار الدوائي لدى الشركة التي تنتجه.
ماذا نفعل للمساعدة؟
إن وصف لك طبيب مضادات حيوية، تأكد من استكمال الفترة الزمنية الكاملة للجرعات حتى وإن شعرت بتحسن ـ لأن عدم استكمال الفترة الزمنية على نحو كامل يشجع على ظهور مقاومة بكتيرية.
تذكر أن المضادات الحيوية أدوية مهمة ولا ينبغي تناولها إلا عندما يوصي بها طبيب متخصص. فهي لا تعمل من أجل العدوى الفيروسية، بل العدوى البكتيرية.
وينصح بعدم مشاركة آخرين في تناول مضاد حيوي.
العناية الصحية الأساسية، مثل غسل اليدين والحرص أثناء إعداد الطعام، يمكن أن يوقف انتشار الكثير من البكتريا، من بينها بعض السلاسات المقاومة.








